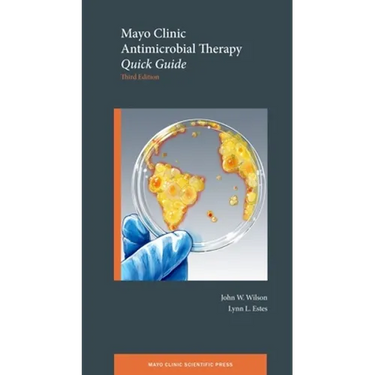

Mayo Clinic Antimicrobial Therapy: Quick Guide - Paperback
Mayo Clinic Antimicrobial Therapy: Quick Guide - Paperback
$107.89
/

products.product.pickup_availability.unavailable
Your payment information is processed securely. We do not store credit card details nor have access to your credit card information.
by John W. Wilson (Author), Lynn L. Estes (Author)
The medical management of infectious diseases and antimicrobial therapy can be a daunting task for health care professionals. Infectious diseases experts at Mayo Clinic provide a coordinated, unified approach to infectious disease treatment for the general patient population as well as the complex patients seen at this internationally renowned destination medical center. Over twenty contributors represent the spectrum of infectious disease experience within the Mayo Clinic framework of patient-centered care. Highlights of Mayo Clinic Antimicrobial Therapy: Quick Guide, Third Edition include simplified and thorough drug dosing recommendations for renal function and renal replacement therapies, drugs of choice for specific organisms (including bacteria, fungi, and viruses), and updated and simplified antimicrobial and management recommendations for specific infectious syndromes. New features of the third edition include dosing recommendations for extended infusions and obese and neonatal patient populations and treatment options targeted for hepatitis B and C infections, prosthetic joint infections, post-transplant infections, and infections resulting from bioterrorism. This compact, user-friendly resource brings the specialized knowledge of Mayo Clinic to your fingertips.
Author Biography
John W. Wilson, MD is a consultant for the Division of Infectious Diseases, Department of Internal Medicine and Associate Professor at Mayo Clinic College of Medicine and Science.
Lynn L. Estes, PharmD is a Infectious Disease Pharmacy, Associate for the Division of Infectious Diseases, Department of Internal Medicine and Assistant Professor of Pharmacy at Mayo Clinic College of Medicine and Science.